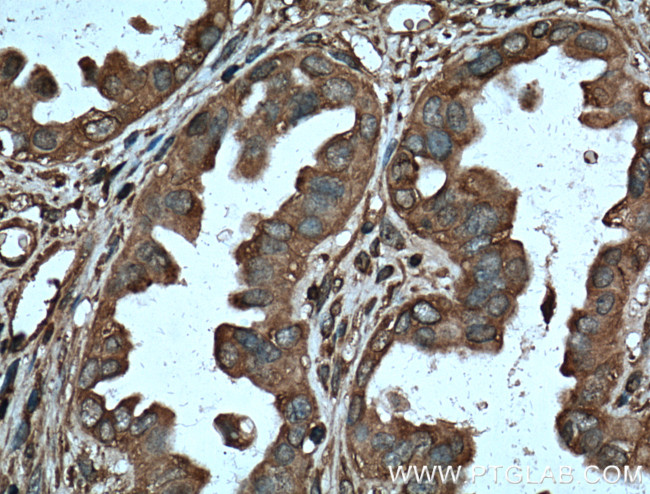
Protein C inhibitor Antibody in Immunohistochemistry (Paraffin) (IHC (P))

Search
Proteintech
Protein C inhibitor Monoclonal Antibody (2H6G2)
{{$productOrderCtrl.translations['antibody.pdp.commerceCard.promotion.promotions']}}
{{$productOrderCtrl.translations['antibody.pdp.commerceCard.promotion.viewpromo']}}
{{$productOrderCtrl.translations['antibody.pdp.commerceCard.promotion.promocode']}}: {{promo.promoCode}} {{promo.promoTitle}} {{promo.promoDescription}}. {{$productOrderCtrl.translations['antibody.pdp.commerceCard.promotion.learnmore']}}
产品信息
66030-1-IG
种属反应
宿主/亚型
分类
类型
克隆号
抗原
偶联物
形式
浓度
规格
纯化类型
保存液
内含物
保存条件
运输条件
产品详细信息
Immunogen sequence: ELHRGFQQL LQELNQPRDG FQLSLGNALF TDLVVDLQDT FVSAMKTLYL ADTFPTNFRD SAGAMKQIND YVAKQTKGKI VDLLKNLDSN AVVIMVNYIF FKAKWETSFN HKGTQEQDFY VTSETVVRVP MMSREDQYHY LLDRNLSCRV VGVPYQGNAT ALFILPSEGK MQQVENGLSE KTLRKWLKMF KKRQLELYLP KFSIEGSYQL EKVLPSLGIS NVFTSHADLS GISNHSNIQV SEMVHKAVVE VDESGTRAAA ATGTIFTFRS ARLNSQRLVF NRPFLMFIVD NNILFLGKVN RP (106-406 aa encoded by BC008915)
靶标信息
This gene encodes a member of the serine proteinase inhibitor (serpin) superfamily. This member is the principal inhibitor of tissue plasminogen activator (tPA) and urokinase (uPA), and hence is an inhibitor of fibrinolysis. Defects in this gene are the cause of plasminogen activator inhibitor-1 deficiency (PAI-1 deficiency), and high concentrations of the gene product are associated with thrombophilia. Alternatively spliced transcript variants encoding different isoforms have been found for this gene.
仅用于科研。不用于诊断过程。未经明确授权不得转售。
篇参考文献 (0)
生物信息学
蛋白别名: Acrosomal serine protease inhibitor; antitr; PAI-3; PCI; Plasma serine protease inhibitor; plasma serine protease inhibitor precursor; Plasminogen activator inhibitor 3; plasminogen activator inhibitor III; plasminogen activator inhibitor-3; Protein C inhibitor; serine (or cysteine) proteinase inhibitor, clade A (alpha-1 antiproteinase, antitrypsin), member 5; Serpin A5; serpin peptidase inhibitor, clade A (alpha-1 antiproteinase, antitrypsin), member 5; unnamed protein product
基因别名: PAI-3; PAI3; PCI; PCI-B; PLANH3; PROCI; SERPINA5
UniProt ID: (Human) P05154
Entrez Gene ID: (Human) 5104